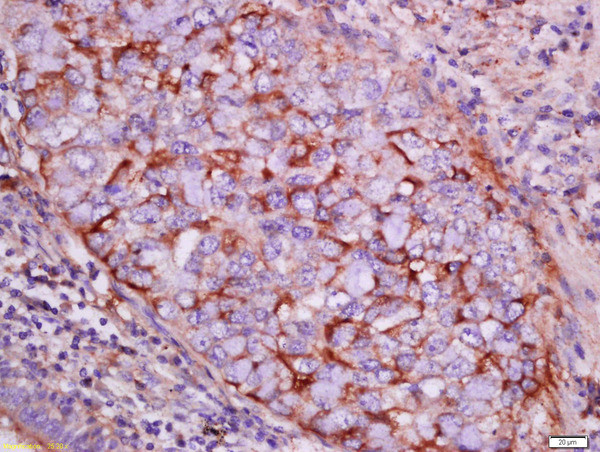
pan-Cytokeratin Antibody in Immunohistochemistry (Paraffin) (IHC (P))

Search
Bioss
pan-Cytokeratin Polyclonal Antibody
{{$productOrderCtrl.translations['antibody.pdp.commerceCard.promotion.promotions']}}
{{$productOrderCtrl.translations['antibody.pdp.commerceCard.promotion.viewpromo']}}
{{$productOrderCtrl.translations['antibody.pdp.commerceCard.promotion.promocode']}}: {{promo.promoCode}} {{promo.promoTitle}} {{promo.promoDescription}}. {{$productOrderCtrl.translations['antibody.pdp.commerceCard.promotion.learnmore']}}
产品信息
BS-2190R
种属反应
宿主/亚型
分类
类型
抗原
偶联物
形式
浓度
规格
纯化类型
保存液
内含物
保存条件
运输条件
靶标信息
Cytokeratins, a group comprising at least 29 different proteins, are characteristic of epithelial and trichocytic cells. Cytokeratins 1, 4, 5, 6, and 8 are members of the type II neutral to basic subfamily. Antibody to cytokeratins are specific markers of epithelial cell differentiation and have been widely used as tools in tumor identification and classification. Anti Pan Cytokeratin (mixture) is a broadly reactive reagent, which recognizes epitopes present in most human epithelial tissues. It facilitates typing of normal, metaplastic and neoplastic cells. Synergy between the various components results in staining amplification. This enables identification of cells, which would otherwise be stained only marginally. The mixture may aid in the discrimination of carcinomas and nonepithelial tumors such as sarcomas, lymphomas and neural tumors. It is also useful in detecting micrometastases in lymph nodes, bone marrow and other tissues and for determining the origin of poorly differentiated tumors. There are two types of cytokeratins the acidic type I cytokeratins and the basic or neutral type II cytokeratins. Cytokeratins are usually found in pairs comprising a type I cytokeratin and a type II cytokeratin. Usually the type II cytokeratins are 8kD larger than their type I counterparts.
仅用于科研。不用于诊断过程。未经明确授权不得转售。
篇参考文献 (0)
生物信息学
蛋白别名: 40-kDa keratin intermediate filament; Cell proliferation-inducing gene 46 protein; CK-18; CK-19; CK-42; cytokeratin 18; cytokeratin 19; Cytokeratin endo B; Cytokeratin-18; Cytokeratin-19; Cytokeratin-42; Endo B; K18; K19; K42; keratin 17n; keratin 18, type I; keratin 19, type I; keratin complex 1, acidic, gene 18; keratin complex 1, acidic, gene 19; Keratin D; Keratin, type I cytoskeletal 18; Keratin, type I cytoskeletal 19; Keratin, type I cytoskeletal 42; keratin, type I, 40-kd; Keratin-17n; Keratin-18; Keratin-19; Keratin-42; krt18 {ECO:0000250|UniProtKB:P05783}; krt42; krt42 {ECO:0000250|UniProtKB:Q6SEK1}; ORF; PIG46; predicted ortholog of type I keratin KA22; Type I keratin Ka19; Type I keratin Ka22; unnamed protein product
基因别名: 2410039E07Rik; AI663979; CK-18; CK18; CK19; CYK18; ecat6; EndoC; K17n; K18; K19; K1CS; Ka19; Ka22; Kerd; Krt-1.19; Krt1-18; Krt1-19; KRT18; KRT19; Krt42; PIG46